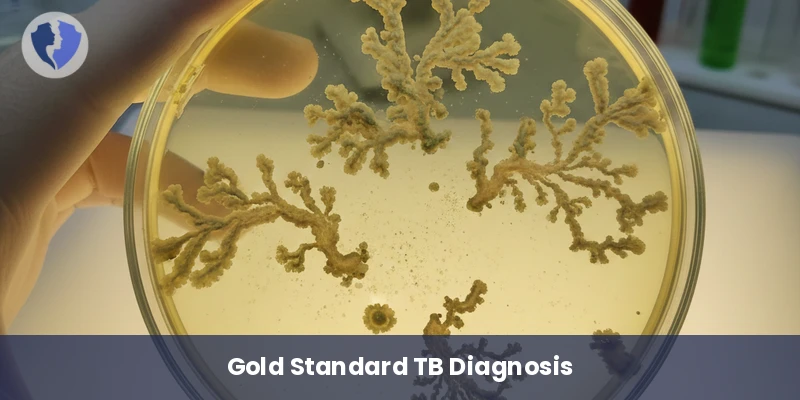
Tuberculosis (TB) Culture

Service Details
Tuberculosis (TB) Culture
Mycobacterium tuberculosis culture is a gold standard laboratory method used to diagnose active tuberculosis infection. It involves culturing a clinical specimen (such as sputum, gastric fluid, urine, or tissue) on special nutrient media (solid, such as Lowenstein-Jensen LJ, or liquid, such as the MGIT system). The aim is to isolate and identify Mycobacterium tuberculosis (MTB) and provide a live sample for drug susceptibility testing (DST), which is crucial for treating drug-resistant tuberculosis.